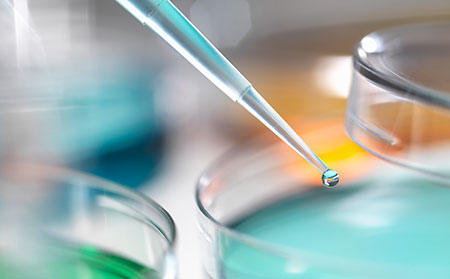
牛皮癬銀屑生物制劑多久可以停藥

患者想知道的治療牛皮癬銀屑病生物制劑的問答
什么是生物制劑?生物制劑治療牛皮癬銀屑病有哪些優勢?
生物制劑是一種單克隆抗體,所謂單克隆抗體就是主要針對某一個分子的靶向藥物。可以比喻成戰斗武器中的追蹤導彈,精準進行目標打擊。而在牛皮癬銀屑病治療里面的傳統一線口服藥物,比如甲氨蝶呤、阿維A或者環孢菌素可能就是大炮或者飛機投彈,目標精準性差,殲滅敵軍同時很容易傷及普通百姓。

因此,生物制劑在牛皮癬銀屑病中有多種好處,包括起效快,療效確切并且有效率高,皮損徹底清除率或者治愈率高。極為重要的是,副作用還非常小,基本上不會影響肝腎功能(傳統藥物經肝腎代謝的,可能會傷肝傷腎,比如甲氨蝶呤的肝毒性較常見,而環孢菌素腎毒性不容忽視)。當然,價格過高是生物制劑極大的缺點,特別在中國,藥物并沒有進入醫保,所以生物制劑是需要患者自己掏腰包的。
治療牛皮癬銀屑病的生物制劑有哪些?
國內目前已經批準的治療牛皮癬銀屑病生物制劑包括:英夫利昔單抗(類克)、阿達木單抗(修美樂)、依那西普單抗(益賽普)、烏司奴單抗(喜達諾)和司庫奇尤單抗(可善挺)。這些藥物都是針劑,其中英夫利昔單抗是需要輸液注射,其他的都是皮下注射(或者肌肉注射)。

因此,英夫利昔單抗是需要住院才能使用的藥物,其他藥物在醫院注射幾次之后且沒有不良反應的話,在保證安全的基礎并且您的主治醫生同意的情況下,可以在家自行注射。其中,英夫利昔單抗、阿達木單抗、依那西普單抗是針對TNF-a的,烏司奴單抗是針對白介素IL-12和23的,而司庫奇尤單抗是針對白介素IL-17A的。
什么樣的牛皮癬銀屑病患者可以考慮生物制劑治療?

我們建議中重度牛皮癬銀屑病患者進行生物制劑治療。輕度的患者還是建議采用外用藥或者外用藥結合光療進行治療即可。通常,對于患者而言,如果牛皮癬銀屑病皮疹面積加起來超過3個巴掌(自己的手掌)大小,可以考慮;如果超過10個巴掌,那就屬于推薦使用生物制劑了。不過由于國內牛皮癬銀屑病價格高昂且不在醫保報銷范圍,因此,個人經濟承受能力也是考慮進行生物制劑的一個重要因素。
什么樣的牛皮癬銀屑病患者不建議進行生物制劑治療?
1:輕度牛皮癬銀屑病患者。
2:有慢性感染性疾病患者(比如乙肝、結核、丙肝、HIV感染)。

3:近兩周有感染性疾病的患者,特別是流感,化膿性扁桃體炎,肺炎,支氣管炎,帶狀皰疹,不明原因發熱等。
4:近期注射過減毒活疫苗的,比如水痘疫苗、帶狀皰疹疫苗、破傷風等疫苗(建議近期注射過疫苗的主動告知您的主治醫生)。
5:有惡性腫瘤病史且仍在治療中。
6:注射期間有懷孕計劃的女性牛皮癬銀屑病患者。
什么類型的牛皮癬銀屑病患者適合用生物制劑治療?
推薦穩定期斑塊狀牛皮癬銀屑病患者使用。不過,對于其他類型牛皮癬銀屑病患者,不少生物制劑也能起到比較好的效果。比如關節型牛皮癬銀屑病對于TNF-a抑制劑或者IL-17A抑制劑反應都是很不錯的。而對于膿皰型、紅皮病型牛皮癬銀屑病,這里也都有相應的治療成功案例。因此生物制劑并不是不能用于其他類型牛皮癬銀屑病。

當然,具體情況還要具體分析。比如針對膿皰型牛皮癬銀屑病,如果是前期有尋常型牛皮癬銀屑病,因為治療不當或者使用偏方突然停藥導致的反跳,從而轉為膿皰型牛皮癬銀屑病的話,那么采用生物制劑是可以的。但是如果患者從來沒有出現過尋常型牛皮癬銀屑病的表現,從開始發病就一直是反復的膿皰型牛皮癬銀屑病的話,那么目前國內的這些生物制劑可能都不推薦。
同樣道理,如果患者的點滴狀牛皮癬銀屑病是因為化膿性扁桃體炎或者其他嚴重感染導致的話,那么生物制劑是暫時不推薦的,只有穩定以后才能使用。但是如果是治療不當或者其他非感染因素導致的,那生物制劑是可以考慮的。
生物制劑治療牛皮癬銀屑病的大概花費是多少需要做什么檢查?
如果嚴格按照推薦方案進行治療,目前多數生物制劑的一年花費在6-10萬左右。其中有效率可能是最高的司庫奇尤單抗首年花費在9.6萬左右。

由于安全性比較好,因此通常是不需要進行反復的肝腎功能和血常規的檢查的。當然,如果出現癥狀隨時要進行相應的檢查。如果沒有任何明顯或者嚴重不適反應,可以3個月左右復查一下血尿常規、肝腎功能,必要的時候可以做一下感染篩查的化驗即可。
生物制劑治療牛皮癬銀屑病中有無效的嗎?會失效嗎?
生物制劑在牛皮癬銀屑病治療中有無效的,不同的藥物無效的比例并不一樣。目前來看,TNF-a抑制劑可能是現有最高的,其次是IL-12/23單抗,最后是司庫奇尤單抗(蘇金單抗)。這也是蘇金單抗在牛皮癬銀屑病病友里面知名度非常高的重要原因。生物制劑治療過程中,有可能會產生抗藥抗體,導致開始的時候有效,后期失效。產生抗藥抗體可能和藥物的性質有關系,通常來說,全人源抗體產生抗藥抗體的比例會比較低,而鼠源性嵌合抗體產生抗藥性比例會比較高。如果治療開始有效,不久后效果不佳,考慮可能是抗藥抗體導致的,建議換藥其他生物制劑或者換成其他治療方案(比如甲氨蝶呤或者環孢菌素)。
常見生物制劑治療牛皮癬銀屑病的不良反應?

最常見的不良反應是注射部位的反應,比如注射部位紅斑,瘙癢,出現風團或者蕁麻疹反應。這種情況最常見于鼠源嵌合抗體或者人源化比例不高的藥物,比如英夫利昔單抗。當然,由于英夫利昔單抗起效非常快速,所以這個藥物仍有非常顯著的優點,并非毫無用武之地。
其次,不良反應主要是各種輕微的感染,比如感冒的發生比例會高一些,有些患者在注射過程會出現帶狀皰疹等。還有一部分患者會感覺到用藥過程中會有輕度犯困或者嗜睡的表現,不過通常不會影響工作,并且后期會減輕。部分患者在開始用藥的時候,皮疹快速消退,會產生輕度的瘙癢感,這個不需要處理。當然,生物制劑還會有一些發生比例很低的罕見副作用,由于比例很低,因此不在這里一一列出,避免增加我們病友的過度焦慮和恐懼的反應。
牛皮癬銀屑病患者用了生物制劑后再用其他藥物是否有效果?
當然不是。生物制劑治療并不會影響牛皮癬銀屑病患者對于其他治療藥物的應答,這是有充分的數據支持的。我用各種生物制劑治療過很多中重度牛皮癬銀屑病患者,確實有些患者后期因為經濟原因,或者因為藥物失效(產生抗藥抗體)而換用其他藥物治療的。
不管是從有效率比較低的生物制劑(比如TNF-a抑制劑)換成有效率更高的生物制劑(比如IL-17A抑制劑),還是從生物制劑換回到傳統藥物(比如甲氨蝶呤或者環孢菌素),都有非常多的成功轉換的案例。開始的生物制劑治療并不會影響后期其他藥物使用的療效和皮損清除率。所以不用有這點擔心和顧慮。
牛皮癬銀屑病用了生物制劑多久可以停藥?
這個問題在國內非常現實,多數牛皮癬銀屑病患者并不能完全按照生物制劑的標準治療一直打下去。所以,濰坊東方銀屑病研究院,如果治療很有效,皮疹已經痊愈或者90%以上消退,并且這種狀態持續3個月以上,可以考慮停用生物制劑,換成其他治療方案。其他搜索:生物制劑是治療銀屑病的希望嗎
【具體治療方案可咨詢濰坊東方銀屑病研究院,謹遵醫囑,切勿自行用藥。如果您無法確定自身病情,可點擊右側咨詢窗口,或撥打我院電話0536-3087125,提供自己的皮膚病照片,我們會為您識別并提供相關治療建議。】
- ·接觸牛皮癬膿水一定會被傳染么
- ·剛起牛皮癬有的什么癥狀 起牛皮癬注意事項
- ·點滴型牛皮癬嚴重嗎 該病的危害有哪些
- ·牛皮癬其實不是真正意義的癬
- ·教你認識牛皮癬的同行反應 牛皮癬同行反應的幾...
- ·告訴你牛皮癬傳染人嗎 牛皮癬的危害
- ·淺談偏方治療牛皮癬的利弊
- ·牛皮癬患者大致分為哪幾個類型?
- ·牛皮癬的遺傳傾向 牛皮癬是否具有遺傳性
- ·成年人牛皮癬有幾種類型
- ·如何降低牛皮癬對壽命的影響
- ·牛皮癬民間偏方大全有哪些
- ·使用牛皮癬軟膏應該注意哪些事項
- ·皮膚牛皮癬的危害有哪些呢
- ·牛皮癬是不是一種傳染性的皮膚病 牛皮癬患者的...
- ·關于牛皮癬的遺傳機率
- ·牛皮癬會給人們帶來怎樣的危害?
- ·小兒牛皮癬的遺傳規律
- ·牛皮癬患者解決失眠的方法
- ·牛皮癬與副牛皮癬一樣嗎?





